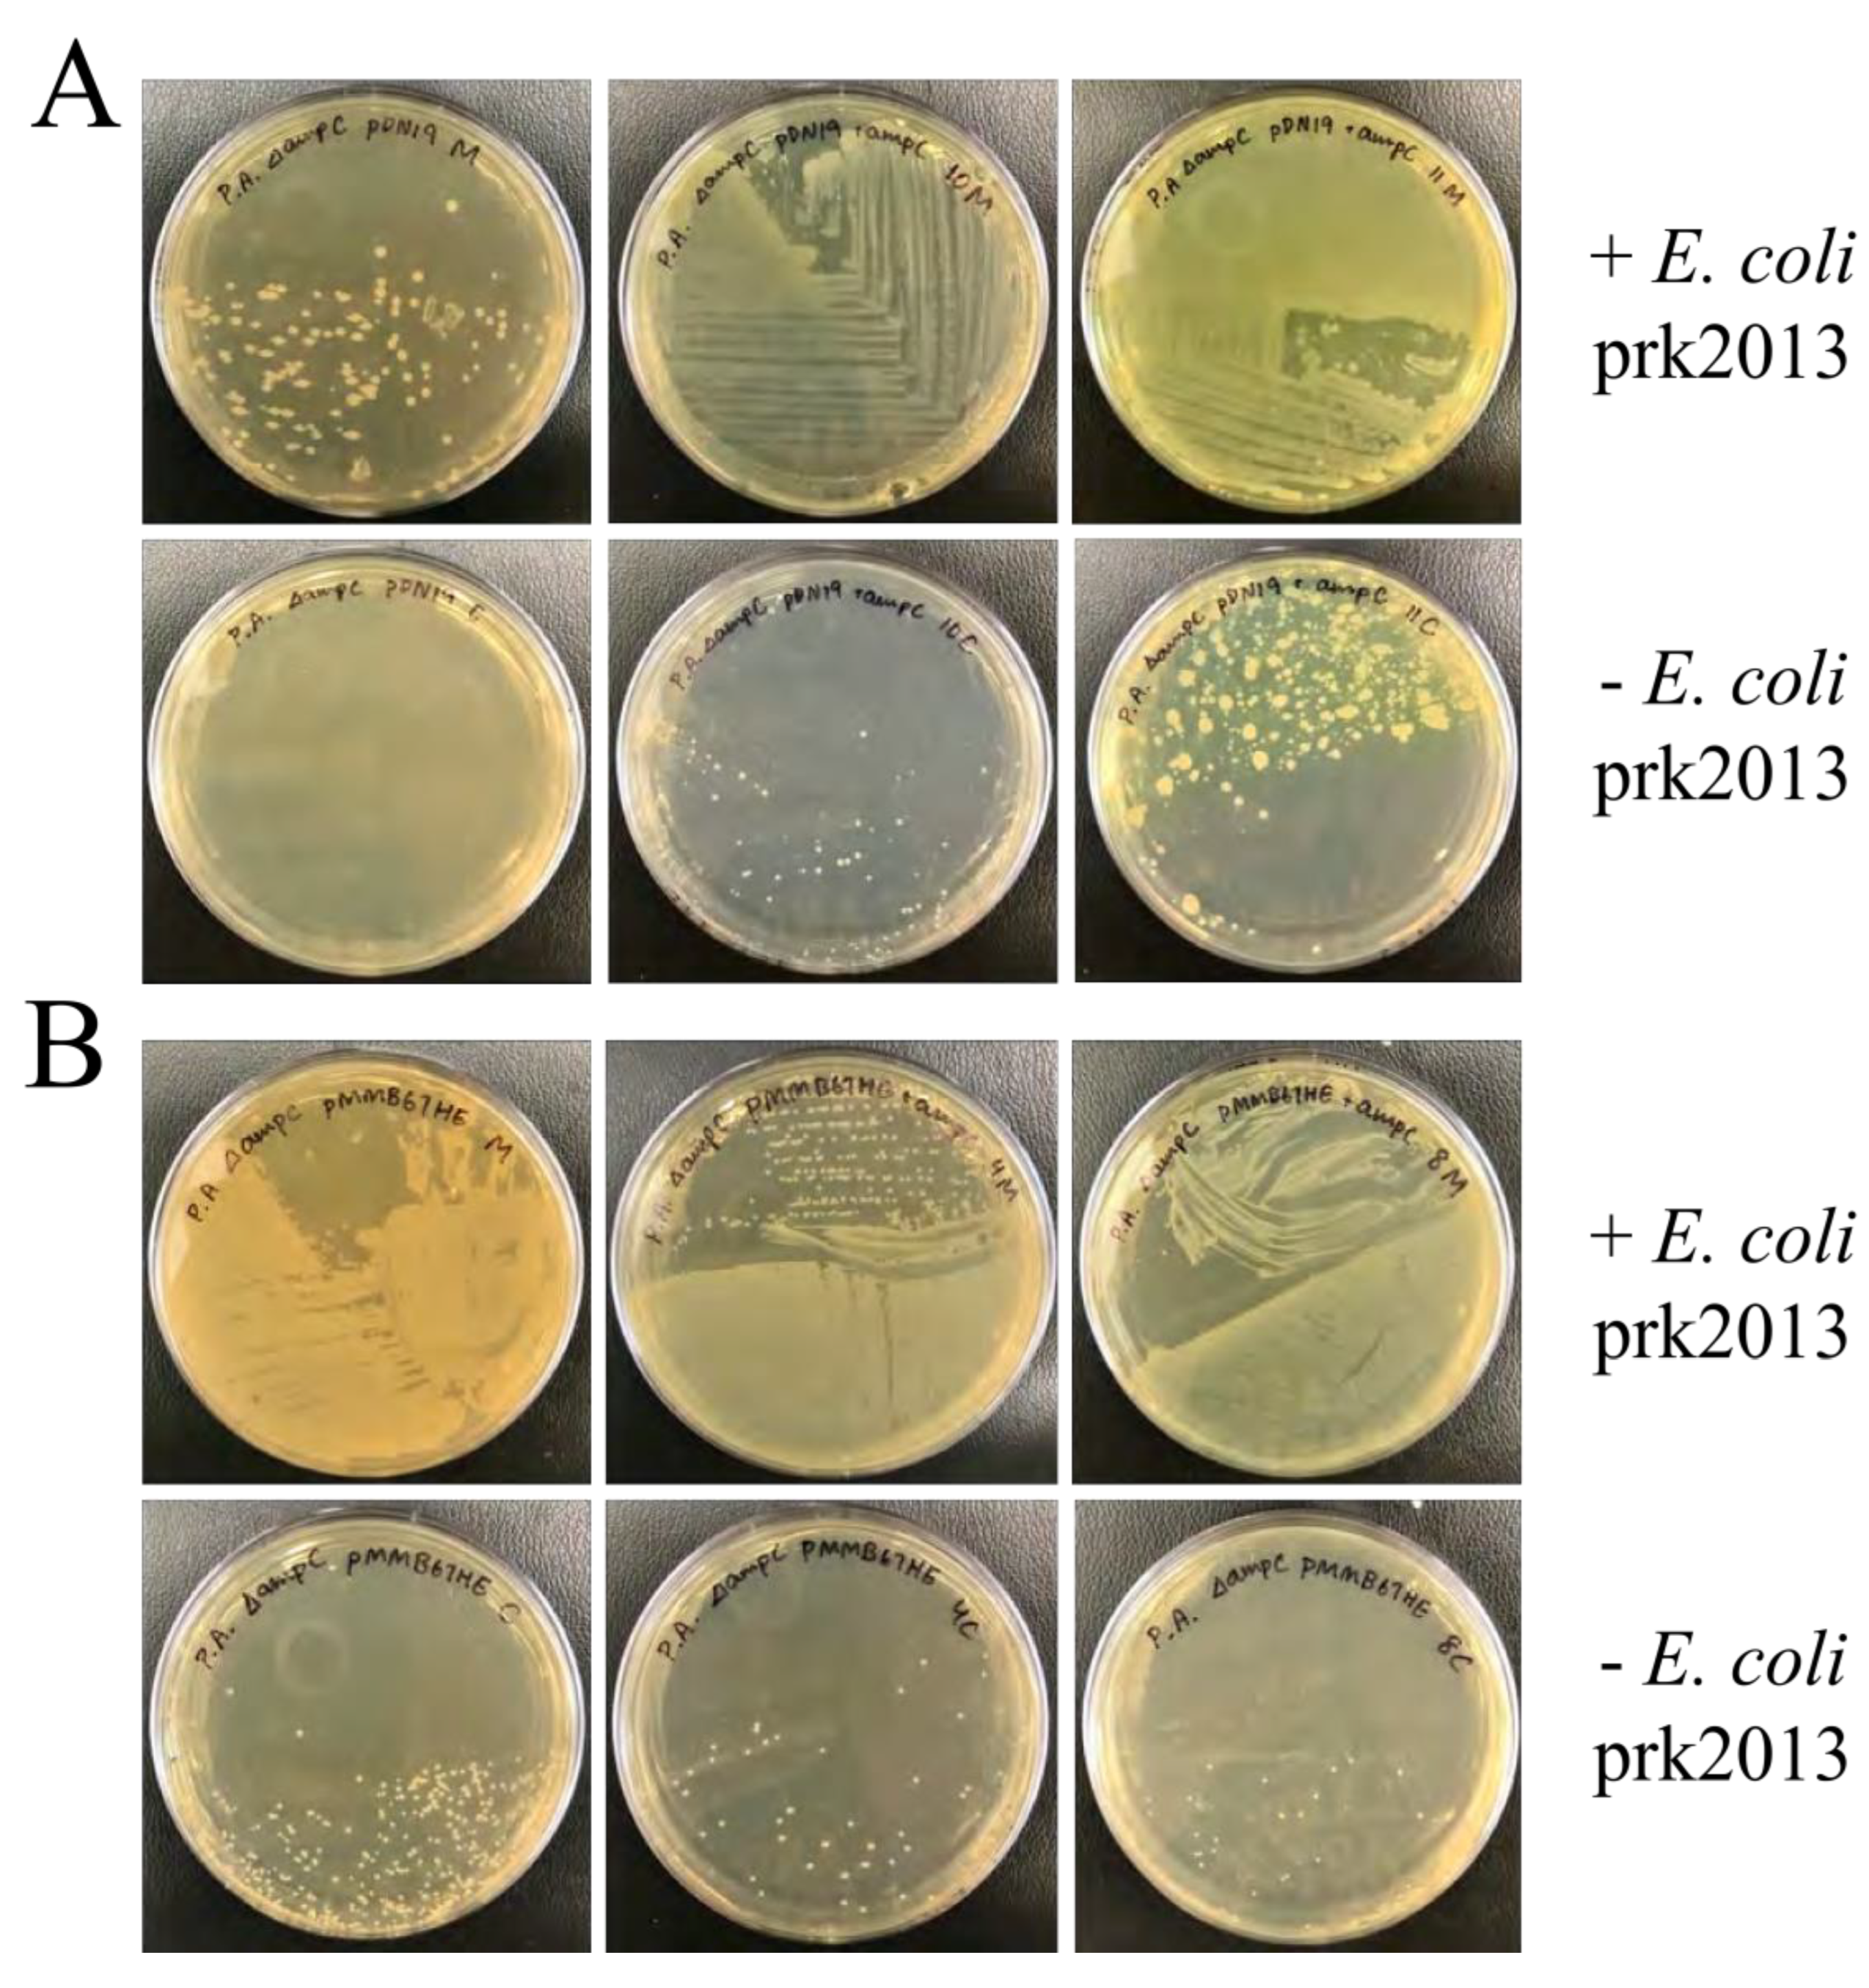
Preprints 137458 g003

Summary
The bacteria Pseudomonas aeruginosa is gaining notoriety in the clinical setting for causing deadly bacterial infections because of its resistance to antibiotics. P. aeruginosa produces an enzyme called β–lactamase that destroys most clinically prescribed antibiotics, including penicillins. Therefore, this study aims to investigate potential binding sites on the β–lactamase protein for novel inhibitors that inactivate this protein. The gene encoding for this protein was replicated into many copies and confirmed for its expression in bacteria. The antibiotic carbenicillin was found best measure the expression of this gene. Future work includes creating mutated copies of the gene and identifying the copies that cause the gene to be expressed incorrectly; this will elucidate on potential sites on the protein that drugs can target to inactivate this protein. This information will be crucial in developing novel therapeutics to treat Pseudomonas infections, which could save thousands of lives annually.
1. Introduction
Infections with bacteria resistant to commonly prescribed antibiotics represent a ma- jor public health crisis. In 2008, the Infectious Diseases Society of America designated a group of antibiotic-resistant bacteria, referred to by the acronym ESKAPE pathogens (
Enterococcus faecium, Staphylococcus aureus, Klebsiella pneumoniae, Acinetobacter baumannii, Pseudomonas aeruginosa, and
Enterobacter), as especially problematic [
1]. The resistance mechanisms of these pathogens belong to three categories: 1. Acquisition and expression of genes encoding antibiotic-inactivating enzymes, 2. Mutations in the target of antibiotics, making them resistant, and 3. Presence and expression of pumps that expel the antibiotics from cells before they reach toxic levels [
2]. The opportunistic pathogen
Pseudomonas aerug- inosa (the P in ESKAPE), in particular, is responsible for a number of acute nosocomial infections and chronic infections such as chronic wounds, urinary tract infections, bacteremia, endocarditis, nosocomial infections, and infections in the lungs of cystic fibrosis (CF) patients [
1,
2]. Furthermore, this organism is difficult to treat due to its high levels of resistance to most clinically useful antibiotics.
P. aeruginosa is best characterized for its resistance to conventional
β–lactam antibi- otics, including penicillins, carbapenems, and cephalosporins [
3]. This is due to the ability of
P. aerugionosa to secrete
β–lactamase, an enzyme that hydrolyzes the
β–lactam ring of
β–lactam antibiotics, thereby inactivating the antibiotic [
2,
3,
4]. Regardless,
β–lactams are still considered desirable therapeutics by physicians due to their low cost and lack of toxicity even at high concentrations [
3]. One solution to renew the effectiveness of
β–lactam an- tibiotics is
β–lactamase inhibitors that are designed to inhibit serine
β–lactamases, thereby restoring the antimicrobial properties of
β–lactams [
4]. However, bacterial species are already beginning to acquire resistance to these inhibitors; avibactam is currently one of the only effective
Pseudomonas β–lactamase inhibitors when prescribed with ceftazidime, and it is already in decline [
5]. While the ceftazidime-avibactam (CAZ-AVI)
β–lactamase inhibitor combination maintains efficacy against
Enterobacteriaceae,
P. aeruginosa has already de- veloped a resistance rate of up to 18% within the first five years of CAZ-AVI’s clinical use (resistance rate defined by the percentage of non-sensitive bacterial isolates) [
5]. This is likely due to
β–lactamase inhibitors’ inactivation mechanism; most
β–lactamase inhibitors exert activity through competitive occupancy of its active site. However, mutations on this enzyme have developed to where the inhibitor can no longer bind to the protein but its respective substrate still maintains these capabilities, rendering the inhibitor ineffective [
6]. Allosteric inhibition, on the other hand, induces a conformational change in the protein of interest, resulting in its complete loss of functionality; this property of allosteric inhibition makes it an ideal strategy for novel
β–lactamase inhibitors. Thus, it is clinically relevant to study the chemical structure and functionality of the
β–lactamase protein to identify new inhibitory sites for
β–lactamase inhibitors.
It is thought that the chromosomal
ampC gene in
Pseudomonas is responsible for the encoding of
β-lactamase, the main mechanism driving
β-lactam antibiotic resistance in
P. aeruginosa [
4]. However, the
ampC gene in
Pseudomonas has not been thoroughly inves- tigated or confirmed for its expression of
β–lactamase. This is likely due to the difficulties involved in studying genes present on bacterial chromosomal DNA; antibiotic resistance genes found on plasmids or other mobile genetic elements can be easily transformed into a host bacterium and is more likely to be expressed. However, it is difficult to study
ampC because it is uncertain how this gene will be expressed when removed from its natural environment and cloned into a plasmid with a different and perhaps incompatible promoter system. For these reasons, the
ampC in
Pseudomonas has never been isolated or studied in a laboratory setting. Therefore, to study the
β-lactamase protein in
Pseudomonas, this experiment aimed to first isolate and clone
ampC of
P. aerugionsa into
E. coli. Furthermore, considering the inefficiency of current
β–lactam antibiotics, the long-term goal of this study was to perform random mutagenesis on
ampC to identify potential allosteric inhibitor sites on
β-lactamase for novel
β-lactamase inhibitors.
2. Methods
2.1. Bacterial Strains, Plasmids, and Media
Wild type Escherichia coli and Pseudomonas aeruginosa were cultured in Luria-Bertani medium. Chromosomal P. aeruginosa PA01 DNA containing the gene of interest (ampC ) was prepared via phenol-chloroform extraction. pDN19 and pMMB67HE plasmid was pu- rified from DH5α E. coli using a plasmid purification kit from Bio Basic (plasmids later utilized as host vectors for recombination of ampC). Recombinant plasmids were introduced in competent DH5α and BL21 E. coli cells then conjugated into ampC deficient strain of P. aeruginosa PAO1 (∆ampC ); conjugation was facilitated by E. coli transformed with pRK2013 plasmid.
For antibiotic susceptibility testing, the following strains of P. aeruginosa were utilized: wild type PAO1 (laboratory strain used to generate ampC deletion), PAO1 ∆ampC, PA14, PA14 Tn-ampC (ampC gene disrupted through insertion of a transposon), PAO1 seq (orig- inal sequenced isolate of P. aeruginosa, and PAO1 seq Tn-ampC (ampC gene disrupted through insertion of a transposon, isogenic to PAO1 seq).
2.2. Cloning the ampC Gene
Restriction enzymes EcoRI (forward) and XbaI (reverse) were utilized to amplify ampC in P. aeruginosa via PCR at an annealing temperature of 64° C and extension time of one minute and twenty seconds.
PCR reactions were carried out using a high fidelity polymerase kit (Q5) Purchased from New England Bio Labs, and molecular size of the amplified ampC insert (1.2 kb) was confirmed using gel electrophoresis (GE) on 1% agarose gels. Ligation of ampC into pMMB67HE and pDN19 was performed using the rapid ligation kit purchased from the same manufacturer.
Recombinant pDN19 plasmids were introduced into competent
E. coli DH5
α and BL21 cells and recombinant pMMB67HE plasmids were introduced into competent
E. coli DH5
α cells by transformation. Sixteen randomly selected
E. coli BL21 and Dh5
α transformants were then selected on Luria-Bertani agar supplemented with tetracycline (10
µg/ml), X-Gal, and Isopropyl ß-D-1-thiogalactopyranoside (IPTG) to perform Blue-White screening [
7,
8,
9] on transformed
E. coli colonies. White colonies were then amplified via colony PCR and run on 1% agarose gels to verify the presence of recombinant plasmid containing the
ampC gene insert.
2.3. Conjugation of P. aeruginosa
Donor recombinant DH5α E. coli cells containing recombinant pDN19 and pMMB67HE plasmids were grown in Luria-Bertani (LB) media supplemented with tetracycline (10 µg/ml).
E. coli carrying prk2013 was cultured in kanamycin (10 µg/ml) and recipient P. aeruginosa δampC was grown in LB media overnight. 1 ml of each cell culture was washed and re- suspended with LB media. Equal volumes of donor, recipient, and E. coli prk2013 cultures were mixed then spotted on LB and incubated for 10-12 at 37°C. Recombinant P. aerug- inosa ∆ampC containing the plasmid of interest were selected on LB agar supplemented tetracycline (30 µg/ml) and irgasan (25 µg/ml).
2.4. β–Lactamase Assay
Wild type P. aeruginosa PAO1 and PA14 strains (both induced and uninduced with 500 µg/ml of penicillin G benzathine) as well as E. coli DH5α and BL21 cells and P. aeruginosa PAO1 ∆ampC transformed with recombinant pMMB67HE and pDN19 plasmids were directly assessed for their β–lactamase producing capabilities to test the expression of the cloned ampC gene. DH5α and BL21 E. coli recombinant cells were suspended in 100 µM phosphate buffer, pH 7. 100 µl of cell suspensions were mixed with equal volumes of colorometric substrate of β–lactamase (nitrocefin, 0.5 mg/ml) and color change of solutions (from yellow to red) were observed after a ten minute incubation at 37°C.
2.5. Antibiotic Susceptibility Testing
Antibiotic Susceptibility Testing (AST) was performed on
E. coli isolates to confirm the expression of
ampC through susceptibility to
β–lactam antibiotics. AST was performed by the Disk diffusion by the Kirby-Bauer method [
10]. Expression of the
ampC gene in
P. aeruginosa was first confirmed by testing pairs of isogenic
P. aeruginosa isolates induced with 50
µg/ml penicillin G benzathine for their susceptibility to
β–lactam antibiotics, including ceftazidime (CAZ, 30
µg/ml), piperacillin (TZP, 110
µg/ml), cefepime (FEP, 30
µg/ml), meropenem (MEM 10
µg/ml), cefotaxime (CTX, 30
µg/ml), and penicillin G benzathine (50
µg/ml).
To identify the antibiotic used for selection of expression of functional β–lactamase, E. coli DH5α and BL21 transformed with recombinant pDN19 and pMMB67HE plasmids were tested for their succeptibility to cefixime (CFM, 10 µg/ml), ampicillin (AMP, 50 µg/ml), carabanicillin (CB, 50 µg/ml), ceftazidime (CAZ, 10µg/ml), gentamicin (GEN, 15 µg/ml), and penicillin G benzathine (PEN 50 µg/ml).
Finally, functional expression of β–lactamase was confirmed in P. aeruginosa ∆ampC transformants, the model that will be used for testing ampC expression during mutagenesis. These strains were tested for their susceptibility to the same antibiotics and concentrations used for E. coli transformants.
A less than 1 cm difference in the inhibition zones between bacterial isolates transformed with plasmid carrying or lacking ampC was used as the criteria for resistance to the β–lactam antibiotics, therefore confirming β–lactamase production and ampC expression.
2.6. Mutagenesis
Random mutagenesis via error prone PCR was conducted on
ampC insert in recombi- nant pMMB67HE plasmid [
11] using the same PCR primers used in cloning of the gene. Mutageneis was conducted through procedures recommended by GeneMorph II random mu- tagenesis kid to yield approximately one mutation per thousand base pairs of DNA of each copy. The presence of the
ampC PCR product was confirmed on 1% agarose gels and products were ligated into pMMB67HE then transformed into
P. aeruginosa ∆
ampC. Carbenicillin was used to select for
ampC copies with expression of functional
β–lactamase.
ampC PCR product DNA was sequenced before and after this selection to identify mutations that affect the expression of functional
β–lactamase.
3. Results
3.1. GE Confirms Successful Cloning of ampC
ampC was successfully amplified via PCR and ligated into pDN19 and pMMB67HE. Presence of PCR product after cutting and cleanup was confirmed on 1% agarose gels, as shown by
Figure 1.
Colony PCR was conducted on 16 randomly selected
E. coli transformants and products were run on 1% agarose gels to confirm presence of recombinant pDN19 and pMMB67HE plasmids and gene insert (
Figure 2). 15 of the 16 randomly selected pMMB67HE colonies and 9 of the 16 pDN19 colonies were successfully transformed with their respective recombinant plasmids.
3.2. Successful Conjugation of P. aeruginosa
P. aeruginosa ∆
ampC was successfully conjugated with pDN19 and pMMB67HE plas- mid. Little growth was observed on control plates without the helper
E. coli prk2013, whereas individual colonies were seen in mating with all three strains, ensuring that selected
Pseu- domonas colonies contained the recombinant plasmids (
Figure 3).
3.3. Induced ampC Produces β–Lactamase
P. aeruginosa PA14 and PAO1 induced with penicillin G produced
β–lactamase, while uninduced strains did not (
Figure 4A). This is likely because expression of
ampC relies on penicillins that are capable of inducing damage to the cell wall without compromising the bacteria.
P. aeruginosa carrying pDN19 with
ampC produced minimal quantities of
β–lactamase, although likely not enough to result in a significant difference in sensitivity to
β–lactams (
Figure 4B). However, both
E. coli and
P. aeruginosa carrying
ampC in the pMMB67HE plasmid both expressed the gene, producing a significant quantities of
β–lactamase (Figures 4C and 4D, respectively). pMMB67HE displayed early signs of promise as a host vector for
ampC ; this is likely because pMMB67HE has its own expression system (tac promoter) within the plasmid, which can lead to much higher system expression.
3.4. Antibiotic Susceptibility Testing Confirms ampC Expression
Antimicrobial susceptibility testing suggested expression of
ampC through susceptibil- ity to penicillin G, as demonstrated by
Table A3, but demonstrated equal susceptibility to cephalasporin antibiotics. This was likely due to inadequate induction of
ampC (50
µg/ml of penicillin G). The additional 50
µg/ml of penicillin added to
P. aeruginosa during AST was likely enough to induce
ampC, explaining why penicillin G was the only antibiotic
P. aeruginosa was resistant to. When
P. aeruginosa was induced with 500
µg/ml of penicillin G, it produced much greater quantities of
β–lactamase (
Figure 4) If antibiotic susceptibility testing was reconducted on isogenic
Pseudomonas, strains containing
ampC would likely confer resistance to most cephalosporins.
Figure 5.
Isogenic Pseudomonas strains treated with ceftazidime (CAZ), priperacillin (TZP), cefepime (FEP), meropnem (FEP), cefotaxime (CTX), and penicillin G (PEN) (ori- entation of antibiotics was the same for all plates). All Pseudomonas strains with ampC were not susceptible to penicillin G compared to strains without ampC.
Figure 5.
Isogenic Pseudomonas strains treated with ceftazidime (CAZ), priperacillin (TZP), cefepime (FEP), meropnem (FEP), cefotaxime (CTX), and penicillin G (PEN) (ori- entation of antibiotics was the same for all plates). All Pseudomonas strains with ampC were not susceptible to penicillin G compared to strains without ampC.
Table 1.
Zones of inhibition (cm) of isogenic P. aeruginosa strains with or without ampC treated with ceftazidime, piperacillin, cefepime, meropenem, ceftotaxime, and penicillin G (pen-G). Pen-G met the requirement for resistance (>1 cm difference in zones of inhibition), thus the expression of ampC was detected.
Table 1.
Zones of inhibition (cm) of isogenic P. aeruginosa strains with or without ampC treated with ceftazidime, piperacillin, cefepime, meropenem, ceftotaxime, and penicillin G (pen-G). Pen-G met the requirement for resistance (>1 cm difference in zones of inhibition), thus the expression of ampC was detected.
| |
Strain |
|
β-lactam
|
PA14 |
PA14 Tn-ampC
|
PAO1 |
PAO1 ∆ampC
|
PAO1 seq |
PAO1 Tn-ampC
|
| Ceftazidime |
2.5 |
3.0 |
2.4 |
3.0 |
2.1 |
4.2 |
| Piperacillin |
2.5 |
3.2 |
2.5 |
3.4 |
2.2 |
3.4 |
| Cefepime |
2.6 |
3.2 |
2.7 |
3.4 |
2.4 |
3.1 |
| Meropenem |
1.9 |
2.8 |
2.7 |
3.1 |
2.7 |
3.0 |
| Cefotaxime |
1.5 |
1.7 |
1.9 |
2.2 |
2.4 |
2.8 |
| Pen-G |
0 |
2.6 |
0 |
3.0 |
0 |
2.8 |
ampC expression was not detected in
E. coli DH5
α and BL21 or
P. aeruginosa ∆
ampC transformants containing pDN19 with
ampC, as revealed in
Table 2. This result is supported by the low levels of
β–lactamase produced by
P. aeruginosa ∆
ampC containing pDN19 with
ampC (
Figure 4B). There did not appear to be a signficant difference in
ampC expression between
E. coli DH5
α and the higher expressing BL21 strain (
Table 2).
ampC expression was detected in
E. coli DH5
α and
P. aeruginosa ∆
ampC containing pMMB67HE with
ampC, supported by their resistance to ampicillin, penicillin G, and car- benicillin (
Table 3). pMMB67HE was determined as the more effective host vector for
ampC gene expression in both
E. coli and
P. aeruginosa.
Carbenicillin was chosen as the antibiotic used for selection of functional
β–lactamase production during mutagenesis. This is because both
E. coli and
P. aeruginosa displayed resistance to carbenicillin and it had the largest difference in zones of inhibition between strains with and without
ampC (
Table 3).
Figure 6.
A. E. coli pMMB67HE recombinants with and without ampC treated with ce- fixime (CFM), gentamicin (GEN), ceftazidime (CAZ), carbenicillin (CB), ampicillin (AMP), and penicillin G (PEN) (orientation of antibiotics was the same for all plates). All E. coli re- combinants with ampC were not susceptible to penicillin G, ampicillin, and carbenicillin com- pared to strains without ampC. B. P. aeruginosa ∆ampC pMMB67HE recombinants with and without ampC treated with cefixime (CFM), gentamicin (GEN), ceftazidime (CAZ), carbenicillin (CB), ampicillin (AMP), and penicillin G (PEN) (orientation of antibiotics was the same for all plates). All P. aeruginosa recombinants with ampC were not susceptible to penicillin G and carbenicillin compared to strains without ampC.
Figure 6.
A. E. coli pMMB67HE recombinants with and without ampC treated with ce- fixime (CFM), gentamicin (GEN), ceftazidime (CAZ), carbenicillin (CB), ampicillin (AMP), and penicillin G (PEN) (orientation of antibiotics was the same for all plates). All E. coli re- combinants with ampC were not susceptible to penicillin G, ampicillin, and carbenicillin com- pared to strains without ampC. B. P. aeruginosa ∆ampC pMMB67HE recombinants with and without ampC treated with cefixime (CFM), gentamicin (GEN), ceftazidime (CAZ), carbenicillin (CB), ampicillin (AMP), and penicillin G (PEN) (orientation of antibiotics was the same for all plates). All P. aeruginosa recombinants with ampC were not susceptible to penicillin G and carbenicillin compared to strains without ampC.
4. Discussion
AmpC
β–lactamase produced by
E. coli was the first bacterial enzyme that destroyed penicillins, the most widely prescribed antibiotic [
12]. However, since then, few studies have explored
ampC -regulated
β–lactamase production in
P. aeruginosa, which is more deadly (responsible for millions of deaths) thus its mechanism is relatively unknown.
In this study, the chromosomal
ampC gene was confirmed to express
β–lactamase in
P. aeruginosa, putting to rest alternative theories of
P. aeruginosa β–lactamase produc- tion being primarily plasmid-mediated [
13]. This study is also the first of its kind to isolate chromosomal
ampC in
P. aeruginosa, clone the gene into a vector, and create a success- ful, self-sustaining system for
ampC expression in both
E. coli and
P. aeruginosa ∆
ampC.
Because pMMB67HE contains its own tac promoter, its expression is not reliant on tran- scription regulators inherent to a specific bacterium [
14]. Furthermore, this vector can easily be regulated by IPTG; for these reasons, this is likely why PMMB67HE was more effective than pDN19. pMMB67HE could be a useful tool to induce expression of
ampC and other chromosomal genes.
pMMB67HE being utilized as the host vector will allow for
ampC expression to be de- tected during mutagenesis. If mutagenesis was conducted on
ampC, potential allosteric bind- ing sites on
β–lactamase would provide groundbreaking insights into developing
β–lactamase inhibitors that inactivate
β–lactamase. Due to the nature of allosteric inhibition, this type of inhibitor would mitigate the possibilities of
P. aeruginosa conferring resistance to it, offer- ing a sustainable solution in combating
Pseudomonas infections. Furthermore, in developing countries where penicillins are more cost-effective, a
β–lactamase inhibitor that renews the efficacy of
β–lactam antibiotics would increase accessibility of
P. aeruginosa therapeutics. This could propel drug discovery in the direction of developing safer therapeutics that remain effective in the long-term. [
15].
5. Future Work
Because ampC was experimentally confirmed as the gene expressing for β–lactamase in P. aeruginosa, and ampC has been isolated and cloned into E. coli, further tests may now be conducted on β–lactamase produced by P. aeruginosa.
Because the pMMB67HE plasmid was identified as the optimal host vector for ampC expression, this plasmid will be used to express ampC during mutagenesis. Furthermore, since the expression in pMMB67HE can be regulated by IPTG, this is a suitable template for mutagenesis. During mutagenesis, copies of ampC will be ligated into pMMB67HE then transformed in P. aeruginosa ∆ampC to test for expression, using carbenicillin as the selecting antibiotic.
The minimum inhibitory concentration (MIC) of carbenicillin on P. aeruginosa will need to be determined in order to identify the concentration of antibiotic required for selection of P. aeruginosa cells producing functional β–lactamase. Mutated copies will be sequenced before and after selection to identify mutations that affect the expression of functional β–lactamase. Relevant mutation sites located in close proximity to one another could act as potential allosteric binding sites for novel β–lactamase inhibitors.
6. Conclusion
ampC was first verified as the gene encoding for β–lactamase in P. aeruginosa by a β–lactamase assay. ampC was then successfully isolated and cloned into E. coli in pDN19 and pMMB67HE plasmids. β–lactamase assays on E. coli recombinants found that ampC produced more β–lactamase when in pMMB67HE compared to pDN19, suggesting greater ampC expression in this pMMB67HE.
Antibiotic susceptibility testing (AST) conducted on recombinant E. coli confirmed this result: no β–lactamse met the criteria for resistance (thus no β–lactamase expression de- tected) for pDN19 containing ampC whereas three β–lactams (ampicillin, pen-G, carbeni- cillin) met the criteria for resistance (thus β–lactamase expression detected) in pMMB67HE. Both recombinant plasmids were conjugated into ampC deficient strain of P. aerug- inosa and β–lactamase assay supported greater production of β–lactamase of ampC in pMMB67HE compared to pDN19 within Pseudomonas. AST on these strains confirmed this result, finding β–lactamase to provide most specificity to carbenicillin in P. aeruginosa. It was concluded that the pMMB67HE plasmid was the optimal host vector for ampC ex- pression, and carbenicillin was selected as the antibiotic used for selection. A functional model of measuring β–lactamase for mutagenesis was thus developed: pMMB67HE ligated with ampC in P. aeruginosa with carbenicillin acting as the selecting antibiotic.
Appendix A
Figure A1.
Figure A1. Primer sequences of forward (EcoRI) and reverse (XbaI) restriction enzymes used for the cleaving of the ampG gene. The underlined segment of the primer sequence highlights sequence of the enzyme’s restriction site.
Figure A1.
Figure A1. Primer sequences of forward (EcoRI) and reverse (XbaI) restriction enzymes used for the cleaving of the ampG gene. The underlined segment of the primer sequence highlights sequence of the enzyme’s restriction site.
Table A1.
Zones of Inhibition (cm) of selected E. coli DH5α pDN19 transformants (10, 11, and 13) treated with cefixime, gentamicin, cephtazadine, carabanicillin, ampicillin, and pen-G.
Table A1.
Zones of Inhibition (cm) of selected E. coli DH5α pDN19 transformants (10, 11, and 13) treated with cefixime, gentamicin, cephtazadine, carabanicillin, ampicillin, and pen-G.
| |
Strain |
|
β-lactam
|
pDN19 |
pDN19 + ampC 10 |
pDN19 + ampC 11 |
pDN19 + ampC 13 |
| Cefixime |
3.5 |
3.7 |
3.7 |
4.2 |
| Gentamicin |
2.4 |
2.0 |
2.0 |
2.2 |
| Cephtazadine |
2.8 |
3.8 |
3.2 |
3.5 |
| Carabanicillin |
3.0 |
3.0 |
3.2 |
3.1 |
| Ampicillin |
1.7 |
2.0 |
1.6 |
1.9 |
| Pen-G |
3.0 |
2.7 |
3.0 |
2.8 |
Table A2.
Zones of Inhibition (cm) of selected E. coli BL21 pDN19 transformants (10 and 11) treated with cefixime, gentamicin, cephtazadine, carabanicillin, ampicillin, and pen-G.
Table A2.
Zones of Inhibition (cm) of selected E. coli BL21 pDN19 transformants (10 and 11) treated with cefixime, gentamicin, cephtazadine, carabanicillin, ampicillin, and pen-G.
| |
Strain |
|
β–lactam
|
pDN19 |
pDN19 + ampC 10 |
pDN19 + ampC 11 |
| Cefixime |
5.2 |
5.0 |
5.0 |
| Gentamicin |
2.7 |
2.0 |
2.8 |
| Cephtazadine |
3.6 |
4.2 |
4.2 |
| Carabanicillin |
3.6 |
3.4 |
4.4 |
| Ampicillin |
2.4 |
2.4 |
2.6 |
| Penicillin G Benzathine |
5.0 |
5.0 |
5.4 |
Table A3.
Zones of Inhibition (cm) of selected E. coli DH5α pMMB67HE transformants (4 and 8) treated with cefixime, gentamicin, cephtazadine, carabanicillin, ampicillin, and pen-G.
Table A3.
Zones of Inhibition (cm) of selected E. coli DH5α pMMB67HE transformants (4 and 8) treated with cefixime, gentamicin, cephtazadine, carabanicillin, ampicillin, and pen-G.
| |
Strain |
|
β–lactam
|
DH5α pMMB67HE |
pMMB67HE + ampC 4 |
pMMB67HE + ampC 8 |
| Cefixime |
2.0 |
0 |
0 |
| Gentamicin |
1.8 |
2.9 |
2.8 |
| Cephtazadine |
3.4 |
2.9 |
3.0 |
| Carabanicillin |
3.8 |
1.5 |
1.5 |
| Ampicillin |
1.9 |
0 |
0 |
| Penicillin G Benzathine |
3.2 |
0 |
0 |
Table A4.
Zones of Inhibition (cm) of selected P. aeruginosa ∆ampC pDN19 transformants (10 and 11) treated with cefixime, gentamicin, cephtazadine, carabanicillin, ampicillin, and pen-G.
Table A4.
Zones of Inhibition (cm) of selected P. aeruginosa ∆ampC pDN19 transformants (10 and 11) treated with cefixime, gentamicin, cephtazadine, carabanicillin, ampicillin, and pen-G.
| |
Strain |
| Beta-lactam |
pDN19 |
pDN19 + ampC 10 |
pDN19 + ampC 11 |
| Cefixime |
0 |
0 |
0 |
| Gentamicin |
2.8 |
2.5 |
2.8 |
| Cephtazadine |
2.4 |
2.6 |
2.6 |
| Carabanicillin |
2.0 |
1.2 |
1.1 |
| Ampicillin |
1.0 |
0.9 |
1.1 |
| Pen-G |
2.6 |
0 |
1.9 |
Table A5.
Zones of Inhibition (cm) of selected P. aeruginosa ∆ampC pMMB67HE transfor- mants (4 and 8) treated with cefixime, gentamicin, cephtazadine, carabanicillin, ampicillin, and pen-G.
Table A5.
Zones of Inhibition (cm) of selected P. aeruginosa ∆ampC pMMB67HE transfor- mants (4 and 8) treated with cefixime, gentamicin, cephtazadine, carabanicillin, ampicillin, and pen-G.
| |
Strain |
|
β-lactam
|
pMMB67HE |
pMMB67HE + ampC 4 |
pMMB67 + ampC 8 |
| Cefixime |
0 |
0 |
0 |
| Gentamicin |
2.6 |
2.9 |
2.8 |
| Cephtazadine |
2.5 |
1.8 |
2.2 |
| Carabanicillin |
2.8 |
0.8 |
1.1 |
| Ampicillin |
0.9 |
0 |
0 |
| Penicillin G Benzathine |
2.4 |
0 |
0 |
References
- G. P. Bodey, R. Bolivar, V. Fainstein, and L. Jadeja. Infections caused by Pseudomonas aeruginosa. Reviews of Infectious Diseases, 5(2):279–313, 1983.
- W.-H. Zhao and Z.-Q. Hu. β-lactamases identified in clinical isolates of Pseudomonas aeruginosa. Critical Reviews in Microbiology, 36(3):245–258, 2010.
- G. F. Gad, R. A. El-Domany, and H. M. Ashour. Antimicrobial susceptibility profile of Pseudomonas aeruginosa isolates in egypt. The Journal of Urology, 180(1):176–181, 2008. [CrossRef]
- C. L. Tooke, P. Hinchliffe, E. C. Bragginton, C. K. Colenso, V. H. Hirvonen, Y. Take- bayashi, and J. Spencer. β-lactamases and β-lactamase inhibitors in the 21st century. Journal of Molecular Biology, 431(18):3472–3500, 2019.
- Y. Wang, J. Wang, R. Wang, and Y. Cai. Resistance to ceftazidime–avibactam and underlying mechanisms. Journal of Global Antimicrobial Resistance, 22:18–27, 2020. [CrossRef]
- E. J. Zasowski, J. M. Rybak, and M. J. Rybak. The β-lactams strike back: Ceftazidime- avibactam. Pharmacotherapy: The Journal of Human Pharmacology and Drug Therapy, 35(8):755–770, 2015.
- Ullmann, F. Jacob, and J. Monod. Characterization by in vitro complementation of a peptide corresponding to an operator-proximal segment of the β-galactosidase structural gene of escherichia coli. Journal of Molecular Biology, 24(2):339–343, 1967. [CrossRef]
- M. E. Brandt, A. H. Gabrik, and L. E. Vickery. A vector for directional cloning and expression of polymerase chain reaction products in Escherichia coli. Gene, 97(1):113– 117, 1991. [CrossRef]
- D. Juers, B. Matthews, and R. Huber. Lacz b-galactosidase: Structure and function of an enzyme of historical and molecular biological importance, 21, 2012.
- J. Hudzicki. Kirby-bauer disk diffusion susceptibility test protocol. American Society for Microbiology, 15:55–63, 2009.
- D. S. Wilson and A. D. Keefe. Random mutagenesis by pcr. Current Protocols in Molecular Biology, 51(1):8–3, 2000.
- G. A. Jacoby. Ampc β-lactamases. Clinical Microbiology Reviews, 22(1):161–182, 2009.
- B. Zhu, P. Zhang, Z. Huang, H.-Q. Yan, A.-H. Wu, G.-W. Zhang, and Q. Mao. Study on drug resistance of pseudomonas aeruginosa plasmid-mediated ampc β-lactamase. Molecular medicine reports, 7(2):664–668, 2013. [CrossRef]
- D. M. Dykxhoorn, R. S. Pierre, and T. Linn. A set of compatible tac promoter expression vectors. Gene, 177(1-2):133–136, 1996. [CrossRef]
- K. Grover. Use of allosteric targets in the discovery of safer drugs. Medical Principles and Practice, 22(5):418–426, 2013. [CrossRef]
Figure 1.
ampC gene amplified by PCR. Gel electrophoresis confirmed presence of ampC to be used for insertion (A.) and ampC to be used for analysis (B.), as demonstrated by the band located between 1.0 and 1.5 kb (circled in red).
Figure 1.
ampC gene amplified by PCR. Gel electrophoresis confirmed presence of ampC to be used for insertion (A.) and ampC to be used for analysis (B.), as demonstrated by the band located between 1.0 and 1.5 kb (circled in red).
Figure 2.
A. Cloning ampC into pDN19 and transformed into E. coli DH5α. Colony PCR of 16 randomly selected DH5α transformants confirmed the presence of the pDN19 recombinant plasmid containing the ampC gene insert, as demonstrated by the band located between 1.0 and 1.5 kb (circled in red). Colonies 5, 10, 11, and 13 were selected on Luria-Bertani agar supplemented with tetracycline (10 µg/ml) and utilized for antibiotic susceptibility testing. B. Cloning ampC into pMMB67HE and transformed into E. coli DH5α. Colony PCR of 16 randomly selected DH5α transformants confirmed the presence of the pMMB67HE recombinant plasmid containing the ampC, as demonstrated by the band located above 1.5 kb (circled in red). Colonies 4, 9, and 10 were selected on Luria-Bertani agar supplemented with tetracycline (10 µg/ml) and utilized for antibiotic susceptibility testing.
Figure 2.
A. Cloning ampC into pDN19 and transformed into E. coli DH5α. Colony PCR of 16 randomly selected DH5α transformants confirmed the presence of the pDN19 recombinant plasmid containing the ampC gene insert, as demonstrated by the band located between 1.0 and 1.5 kb (circled in red). Colonies 5, 10, 11, and 13 were selected on Luria-Bertani agar supplemented with tetracycline (10 µg/ml) and utilized for antibiotic susceptibility testing. B. Cloning ampC into pMMB67HE and transformed into E. coli DH5α. Colony PCR of 16 randomly selected DH5α transformants confirmed the presence of the pMMB67HE recombinant plasmid containing the ampC, as demonstrated by the band located above 1.5 kb (circled in red). Colonies 4, 9, and 10 were selected on Luria-Bertani agar supplemented with tetracycline (10 µg/ml) and utilized for antibiotic susceptibility testing.
Figure 3.
P. aeruginosa ∆ampC and E. coli matings. A. Matings of P. aeruginosa ∆ampC and E. coli carrying pDN19. Colony growth was significantly larger in matings supplemented with E. coli prk2013 (top row) compared to without (bottom row), indicating that most se- lected P. aeruginosa colonies were truly conjugated. B. Matings of P. aeruginosa ∆ampC and E. coli recombinant pMMB67HE (pMMB67HE + ampC ). Colony growth was signifi- cantly larger in matings supplemented with E. coli prk2013 (top row) compared to without (bottom row), indicating that most selected P. aeruginosa were truly conjugated.
Figure 3.
P. aeruginosa ∆ampC and E. coli matings. A. Matings of P. aeruginosa ∆ampC and E. coli carrying pDN19. Colony growth was significantly larger in matings supplemented with E. coli prk2013 (top row) compared to without (bottom row), indicating that most se- lected P. aeruginosa colonies were truly conjugated. B. Matings of P. aeruginosa ∆ampC and E. coli recombinant pMMB67HE (pMMB67HE + ampC ). Colony growth was signifi- cantly larger in matings supplemented with E. coli prk2013 (top row) compared to without (bottom row), indicating that most selected P. aeruginosa were truly conjugated.
Figure 4.
Color change from yellow to red after ten minutes upon addition of nitrocefin revealed production of β–lactamase. A. P. aeruginosa PAO1 and PA14 induced with peni- cillin G (+) changed colors from yellow to light red and deep red (respectively), confirming their production of β–lactamase. B. P. aeruginosa ∆ampC conjugated with pDN19 did not change colors while P. aeruginosa conjugated with pDN19 containing ampC changed colors slightly from yellow to light orange. This color change was insufficient to confirm β– lactamase production. C. E. coli carrying pMMB67HE did not change colors while E. coli containing pMMB67HE with ampC changed colors significantly to dark red. This confirmed β–lactamase expression in E. coli transformants carrying ampC. D. P. aeruginosa ∆ampC carrying pMMB67HE did not change colors while P. aeruginosa carrying pMMB67HE with ampC changed colors significantly to dark red. This confirmed β–lactamase expression in P. aeruginosa conjugates with ampC.
Figure 4.
Color change from yellow to red after ten minutes upon addition of nitrocefin revealed production of β–lactamase. A. P. aeruginosa PAO1 and PA14 induced with peni- cillin G (+) changed colors from yellow to light red and deep red (respectively), confirming their production of β–lactamase. B. P. aeruginosa ∆ampC conjugated with pDN19 did not change colors while P. aeruginosa conjugated with pDN19 containing ampC changed colors slightly from yellow to light orange. This color change was insufficient to confirm β– lactamase production. C. E. coli carrying pMMB67HE did not change colors while E. coli containing pMMB67HE with ampC changed colors significantly to dark red. This confirmed β–lactamase expression in E. coli transformants carrying ampC. D. P. aeruginosa ∆ampC carrying pMMB67HE did not change colors while P. aeruginosa carrying pMMB67HE with ampC changed colors significantly to dark red. This confirmed β–lactamase expression in P. aeruginosa conjugates with ampC.
Table 2.
Average zones of inhibition (cm) of E. coli DH5α and BL21 and P. aeruginosa. ∆ampC transformants with cefixime, gentamicin, ceftazidime, carbenicillin, ampicillin, and penicillin G (Pen-G). No β–lactam met the criteria for resistance, thus expression of ampC was not detected in either E. coli DH5α or BL21.
Table 2.
Average zones of inhibition (cm) of E. coli DH5α and BL21 and P. aeruginosa. ∆ampC transformants with cefixime, gentamicin, ceftazidime, carbenicillin, ampicillin, and penicillin G (Pen-G). No β–lactam met the criteria for resistance, thus expression of ampC was not detected in either E. coli DH5α or BL21.
| |
Strain |
| DH5α
|
|
BL21 |
|
∆ampC
|
|
β-lactam
|
pDN19 |
pDN19 + ampC
|
pDN19 |
pDN19 + ampC
|
pDN19 |
pDN19 + ampC
|
| Cefixime |
3.5 |
3.9 |
5.2 |
5.0 |
0 |
0 |
| Gentamicin |
2.4 |
2.1 |
2.7 |
2.4 |
2.8 |
2.7 |
| Ceftazidime |
2.8 |
3.5 |
3.6 |
4.2 |
2.4 |
2.6 |
| Carabanicillin |
3.0 |
3.1 |
3.6 |
3.9 |
2.0 |
1.2 |
| Ampicillin |
1.7 |
1.8 |
2.4 |
2.5 |
1.0 |
1.0 |
| Pen-G |
3.0 |
2.8 |
5.0 |
5.2 |
2.6 |
1.4 |
Table 3.
Zones of Inhibition (cm) of E. coli DH5α and P. aeruginosa ∆ampC pMMB67HE transformants treated with cefixime, gentamicin, ceftazidime, carbenicillin, ampicillin, and penicillin G (Pen-G). Carbenicillin and pen-G met the criteria for resistance for both P. aeruginosa and E. coli transformants while carbenicillin met the criteria for resistance in E. coli ; expression of ampC was thus detected in both bacteria.
Table 3.
Zones of Inhibition (cm) of E. coli DH5α and P. aeruginosa ∆ampC pMMB67HE transformants treated with cefixime, gentamicin, ceftazidime, carbenicillin, ampicillin, and penicillin G (Pen-G). Carbenicillin and pen-G met the criteria for resistance for both P. aeruginosa and E. coli transformants while carbenicillin met the criteria for resistance in E. coli ; expression of ampC was thus detected in both bacteria.
| |
Strain |
| DH5α
|
|
∆ampC
|
|
β–lactam
|
pMMB67HE |
pMMB67HE + ampC
|
pMMB67HE |
pMMB67HE + ampC
|
| Cefixime |
2.0 |
0 |
0 |
0 |
| Gentamicin |
1.8 |
2.9 |
2.6 |
2.9 |
| Ceftazidime |
3.4 |
3.0 |
2.5 |
2.0 |
| Carbenicillin |
3.8 |
1.5 |
2.8 |
1.0 |
| Ampicillin |
1.9 |
0 |
0.9 |
0 |
| Pen-G |
3.2 |
0 |
2.4 |
0 |
|
Disclaimer/Publisher’s Note: The statements, opinions and data contained in all publications are solely those of the individual author(s) and contributor(s) and not of MDPI and/or the editor(s). MDPI and/or the editor(s) disclaim responsibility for any injury to people or property resulting from any ideas, methods, instructions or products referred to in the content. |
© 2024 by the authors. Licensee MDPI, Basel, Switzerland. This article is an open access article distributed under the terms and conditions of the Creative Commons Attribution (CC BY) license (http://creativecommons.org/licenses/by/4.0/).